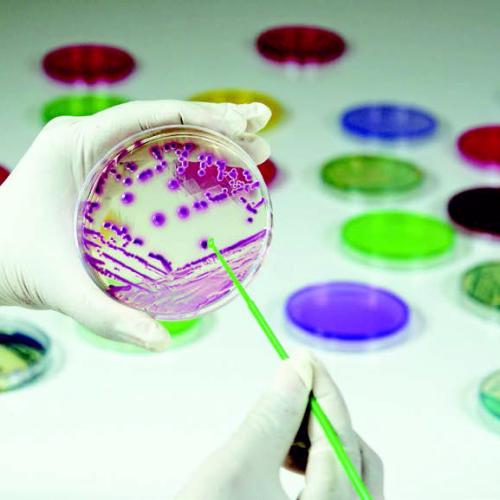
Агар с бараньей кровью, чашки 90 мм MP1301

Агар с бараньей кровью, чашки 90 мм
Описание
Для культивирования прихотливых микроорганизмов и изучения гемолитических реакций. Обеспечивает улучшенный и усиленный гемолиз.
Доступные фасовки: MP1301-20PT, MP1301-50PT
Доступные фасовки: MP1301-20PT, MP1301-50PT
Характеристики
Области применения
Документация
HiMedia Laboratories Pvt. Ltd. - абсолютный лидер по ассортименту поставляемых питательных сред.